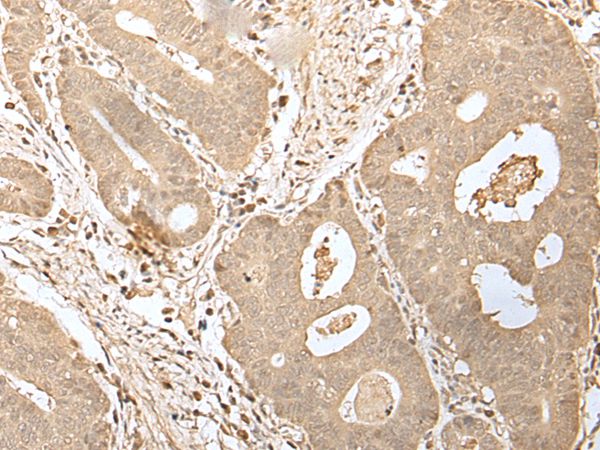
Product Image
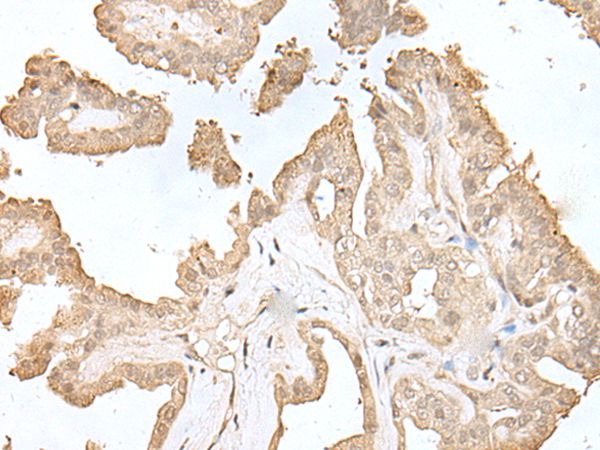
Product Image

Anti-HDHD2 Antibody
A44452
ApplicationsWestern Blot, ImmunoHistoChemistry
Product group Antibodies
ReactivityHuman
Overview
- SupplierAntibodies.com
- Product NameAnti-HDHD2 Antibody
- Delivery Days Customer7
- ApplicationsWestern Blot, ImmunoHistoChemistry
- CertificationResearch Use Only
- ClonalityPolyclonal
- Concentration1 mg/ml
- ConjugateUnconjugated
- HostRabbit
- Scientific DescriptionRabbit polyclonal antibody to HDHD2
- ReactivityHuman
- UNSPSC12352203

![WB analysis of HEK293T cells transfected with HDHD2 plasmid (Right) or empty vector (Left) for 48 hrs using GTX84376 HDHD2 antibody [2C12]. Loading : 5 ug per lane](https://www.genetex.com/upload/website/prouct_img/normal/GTX84376/GTX84376_4323_WB_w_23061420_399.webp)
